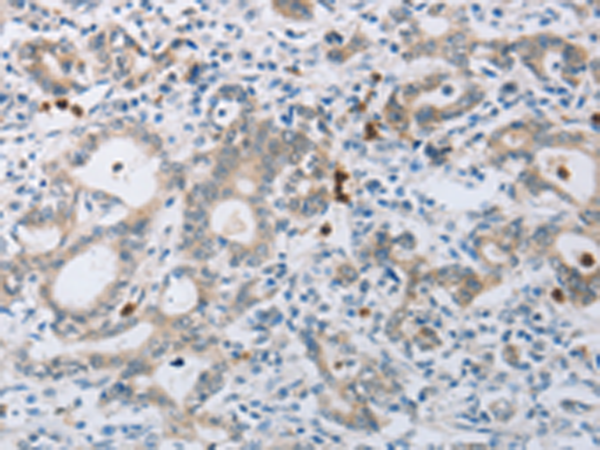

中文名稱: 兔抗ABCB9多克隆抗體
英文名稱: Anti-ABCB9 rabbit polyclonal antibody
別 名: TAPL, EST122234
相關(guān)類別: 一抗
儲 存: 冷凍(-20℃)
宿 主: Rabbit
抗 原: ABCB9
反應(yīng)種屬: Human
標(biāo) 記 物: Unconjugate
克隆類型: rabbit polyclonal
技術(shù)規(guī)格
|
Background: |
The membrane-associated protein encoded by this gene is a member of the superfamily of ATP-binding cassette (ABC) transporters. ABC proteins transport various molecules across extra- and intra-cellular membranes. ABC genes are divided into seven distinct subfamilies (ABC1, MDR/TAP, MRP, ALD, OABP, GCN20, White). This protein is a member of the MDR/TAP subfamily. Members of the MDR/TAP subfamily are involved in multidrug resistance as well as antigen presentation. This family member functions in the translocation of peptides from the cytosol into the lysosomal lumen. Alternative splicing of this gene results in distinct isoforms which are likely to have different substrate specificities. |
|
Applications: |
ELISA, WB, IHC |
|
Name of antibody: |
ABCB9 |
|
Immunogen: |
Synthetic peptide of human ABCB9 |
|
Full name: |
ATP-binding cassette, sub-family B (MDR/TAP), member 9 |
|
Synonyms: |
TAPL, EST122234 |
|
SwissProt: |
Q9NP78 |
|
IHC positive control: |
Human gastric cancer and human breast cancer |
|
IHC Recommend dilution: |
15-50 |
|
WB Predicted band size: |
84 kDa |
|
WB Positive control: |
Hela cells |
|
WB Recommended dilution: |
200-1000 |

購物車
購物車 幫助
幫助
 021-54845833/15800441009
021-54845833/15800441009
